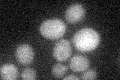
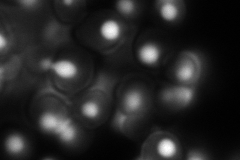

View description
Exosome core complex catalytic subunit; possesses both endonuclease and 3'-5' exonuclease activity; involved in 3'-5' RNA processing and degradation in both the nucleus and the cytoplasm; has similarity to E. coli RNase R and to human DIS3
Localization:
Intensity:
Fold change:
Significance:
-
C’ GFP library in SD
below threshold16.52 -
N' NOP1pr-GFP in SD
nucleus164.187 -
N' TEF2pr-mCherry in SD

cell periphery,vacuole163.921 -
N' NATIVEpr-GFP in SD

nucleus,nucleolus71.4342 -
N' TEF2pr-VC and Cyto-VN in SD

#N/A0 -
C’ GFP library in SD+DTT

cytosol14.530.87No -
C’ GFP library in SD+H2O2

cytosol18.981.14No -
C’ GFP library in Starvation Media

cytosol16.881.02No -
C’ GFP library on the background of Pup2-DaMP

below threshold -
C’ GFP library on the background of CCT mutant

below threshold16.72751.01192No
